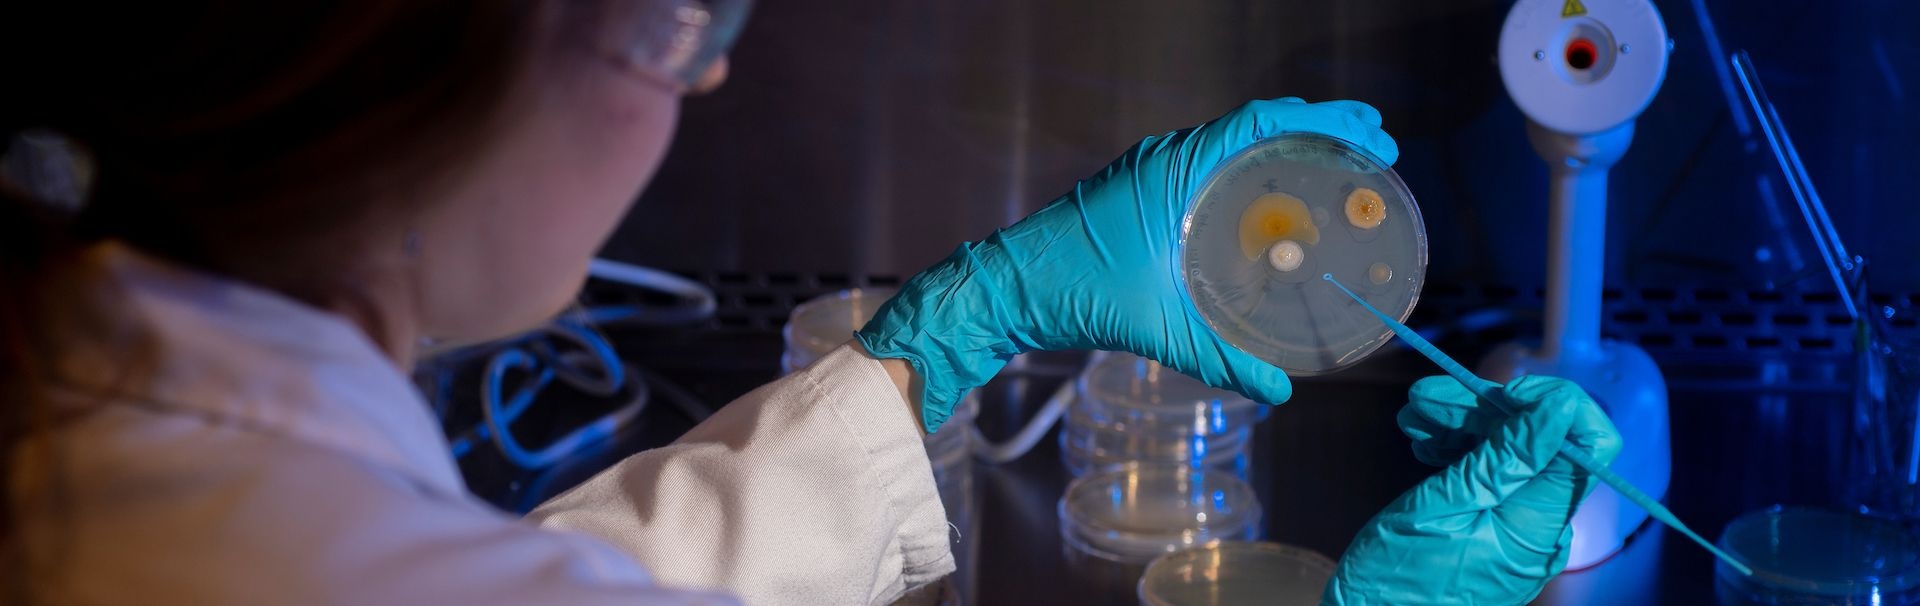

Welcome to the Department of Biology and Marine Biology!

When you graduate as a major from our department, you will have all the skill sets and training that you will need for the next step in your life: a job in your field, or attendance at a graduate or professional school.
Our Degree Programs
Other Resources
College & Department News
Contact Us
Department of Biology and Marine Biology
601 South College Road
Dobo Hall, 1010
Wilmington, NC 28403-5915